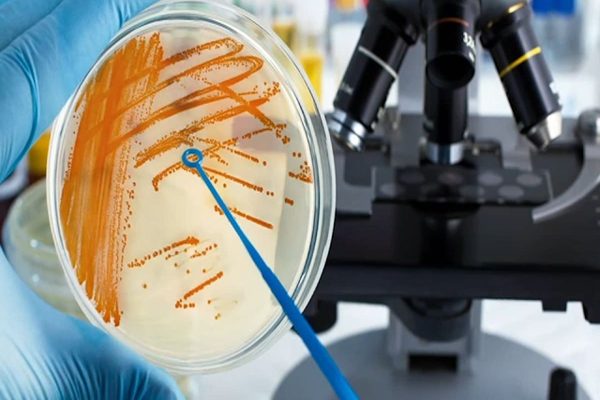
چرا عفونت‌های کشنده و تهاجمی در کانادا در حال افزایش است

وقتی «کالین هانتر»، بهار گذشته دچار گلودرد و تب شد، زیاد جدي نگرفت. یک هفته بعد، بعد از بستهبندی و باز کردن جعبههای مقوایی، انگشت میانی دست راستش کمی درد گرفت. تا اواسط بعدازظهر، ورم کرده بود. و تا اوایل شب معلوم بود كه يك اتفاق عجيبي در حال رخ دادن است شاید یک نوع عفونتهای کشنده! هانتر به یاد میآورد: «حدود ساعت ۵ بعدازظهر، حس كردم تودهاي شبيه يك انگور بزرگ انتهای انگشتم درآمد كه سياه بود. از هر طرف، اطراف ناخنم متورم میشد و انگار نبض داشت ميتپيد. همان موقع بود که به اورژانس رفتم».
پزشکان در بیمارستان محلی ميترسيدند كه مبادا اين مورد فاسییت نکروزان باشد که ازش به عنوان بیماری گوشتخوار نیز ياد میشود. بنابراین انگشتش را بریدند، آزمایشهایی انجام دادند و با تشخیص شگفتانگیزی اعلام كردند كه او عفونت استرپتوکوکی A داشته است.
هانتر هرگز تا حالا چنين چيزي را در دست كسي نديده بود. سپس متوجه شد که گلودرد و تب قبلیاش ممکن است یک مورد تشخیص داده نشده گلودرد استرپتوکوکی بوده عفونت استرپتوکوکی A میتواند از طریق چیزی به کوچکی یک برش کاغذ به داخل انگشتش نفوذ کرده باشد.
این شهروند ۴۷ ساله گوئلف، ساکن اونت، در نهایت پنج روز را صرف تزريق آنتیبیوتیکهای داخل وریدی کرد. پزشکان در طول اقامتش در بیمارستان، گفتند که عفونت استرپتوکوکی A احتمالاً از طریق جریان خون او پخش میشود. او پس از درمان در بیمارستان و مصرف یک دور دیگر آنتیبیوتیک در خانه بهبودی کامل پیدا کرد. اما چیزی که اکنون هانتر را آزار میدهد این است که اگر به محض اینکه دستش متورم شد به پزشك مراجعه نميكرد، اكنون چه بلايي سرش آمده بود. تنفسی
شیوع عفونتهای کشنده استرپتوکوکی A در سراسر جهان
آنطور که سیبیسی نیوز برای اولین بار هفته گذشته گزارش داد، عفونت استرپتوکوکی A با شیوع سریع و بالقوه کشنده – معروف به گروه مهاجم استرپتوکوکی A یا iGAS – در کانادا در حال افزایش است. همچنین این نوع عفونتهای کشنده در سال ۲۰۲۳ به بالاترین حد خود رسیده است.
ايالتهاي مختلف همچنین دهها مورد مرگومير را در چند ماه گذشته گزارش کردهاند، از جمله مرگ حداقل ده کودک در سراسر انتاریو و بریتیش کلمبیا. کشورهای دیگر مانند بریتانیا و ژاپن نیز افزایش مرگومير قابل توجهی را گزارش کردهاند.
حالا سوال بزرگ این است: چرا؟ چرا در کانادا و خارج از کشور شاهد افزایش این عفونتهای کشنده هستیم؟
دانشمندان میگویند که هیچ مدرك مسلمي وجود ندارد، بلکه پاي مجموعهای پیچیده از عوامل در ميان است که برخی از آنها حتی قبل از همهگیری کوويد -۱۹ ظاهر شدند.
دکتر «جنیفر گوتری»، استادیار میکروبیولوژی و ایمونولوژی در دانشگاه وسترن لندن در این باره گفت: «ما در حال حاضر به طور کامل این موضوع را درک نمیكنیم. و احتمالا درک این موضوع همراه با افزایش جمعیت، جديتر شود.»
سالها بود که ميزان مرگوميرهاي عفوني به آرامی بالا میرفت
عفونت استرپتوکوکی A خانوادهای از باکتریها هستند که معمولاً باعث بیماریهای خفیفتر مانند گلودرد دردناک استرپتوکوکی، عفونتهای پوستی یا مخملک میشوند. در این موارد، مصرف آنتیبیوتیکها معمولا همه چیز را برطرف میکنند.
شکل تهاجمی زمانی رخ میدهد که باکتری استرپتوکوک وارد بافت نرم یا جریان خون میشود. «مایکل جانسون»، دانشیار دپارتمان ایمونوبیولوژی دانشگاه آریزونا، میگوید: «این بيماري همچون بزرگراهي به هر نقطه از بدن شما نفوذ ميكند.»
عفونت استرپتوکوکی A، کشندهتر از هر نوع عفونت دیگر!
عفونت استرپتوکوکی A، اگرچه نسبتاً نادر است، اما این عفونتهای iGAS اغلب به سرعت پیشرفت میکنند. همچنین منجر به طیف وسیعی از بیماریهای جدی از سندرم شوک سمی گرفته تا سپسیس و التهاب مغز میشوند. جانسون خاطرنشان کرد: «در میان انواع مختلفی از باکتریهایی که میتوانند انسان را بیمار کنند، عفونت استرپتوکوکی A احتمالاً بیش از هر نوع دیگری باعث انواع بیماریها میشود.»
بیشتر تخمینها حاکی از آن است که حدود یک نفر از هر ده نفر در طول ۱۲ تا ۲۴ ساعت از ابتلا به iGAS میمیرند.
تحقیقات نشان میدهد که میزان عفونتهای کشنده سالها به آرامی در حال افزایش بوده است. یک مطالعه کانادایی که در سپتامبر ۲۰۲۲ منتشر شد، از یک پایگاه داده ملی نظارت بر بیماریها جهت بررسی نرخ iGAS بین سالهای ۲۰۰۹ تا ۲۰۱۹ استفاده کرد.
این تیم، از جمله دکتر «آلیسون مکگر» محقق دانشگاه تورنتو و متخصص بیماریهای عفونی، دریافتند که شیوع این عفونتها از چهار مورد در هر ۱۰۰ هزار نفر به کمی بیش از هشت برابر رسيده كه تنها در يك دهه دوبرابر شده است. آخرین آمار از ۴۶۰۰ نمونه iGAS پردازش شده برای سال ۲۰۲۳ که توسط آژانس بهداشت عمومی کانادا در اختیار CBC News قرار گرفته، نشان میدهد که این میزان اکنون میتواند به ۱۲ مورد در هر ۱۰۰ هزار نفر برسد.
مکگر به سیبیسی نیوز گفت که نظریههای متعددی در مورد این افزایش وجود دارد.
علت شیوع باکتریهای نوع استرپتوکوکی
خانواده باکتریهای پشت بیماریهای مرتبط با استرپتوکوک اغلب در محیطهای تجمعی از جمله تسهیلات مراقبتی طولانی مدت و سیستم پناهگاه رشد میکنند، زیرا از طریق تماس نزدیک از جمله زخم های باز و قطرات هوابرد ناشی از سرفه، صحبت کردن یا عطسه فرد گسترش مییابند.
بنابراین گمانهزنیها حاکی از آن است که افزایش سطح بیخانمانی و مصرف مواد مخدر وریدی در کانادا میتواند به معنای زندگی بیشتر افراد در شرایطی باشد که در آن استراحت بیشتری در پوست و مشکلات دسترسی به بهداشت خوب وجود داشته باشد و این جمعیت را در برابر عفونت های استرپ آسیبپذیر کند.
دکتر ایوان یینگ، پزشک بیماریهای عفونی در Mackenzie Health، شبکه بیمارستانی در شمال تورنتو، گفت: «با توجه به افزایش چشمگیر گردشگری بینالمللی در 20 سال منتهی به همهگیری، سفرهای جهانی ممکن است عامل دیگری باشد.»
يینگ گفت: «من فکر میکنم سفر، محیطهای بسته، و سویههای مختلفی که از مرز عبور میکنند، ميتوانند با اين افزايش ارتباط داشته باشند.»
طوفان کامل عفونتهای تنفسی و باکتریایی
محدودیتهای بهداشت عمومی اعمال شده برای مهار انتقال SARS-CoV-2، ویروسی که در پشت كوويد 19۱۹قرار دارد، بر سایر پاتوژنها نیز اثر موجی داشت. آنفولانزا برای بیش از یک سال ناپدید شد. چندین کشور کاهش نرخ بیماری پنوموکوکی را گزارش کردند.
مک گیر گفت: «عفونت استرپتوکوکی ۵۰A تا ۶۰ درصد برای یک سال و نیم آینده کاهش یافت.»
مثلا در بريتيش كلمبيا،چهار مورد مرگ و میر ناشی از استرپ در میان کودکان شامل دو مورد بود که استرپ گروه A در کنار آنفولانزا شناسایی شد. دو مورد دیگر که در کنار یک بیماری تنفسی ویروسی دیگر به نام متاپنومویروس انسانی شناسایی شد.
مک گر خاطرنشان کرد: «یک قطعه از این پازل ممکن است این واقعیت باشد که عفونتهای استرپتوکوکی میتوانند به سلولهای دستگاه تنفسی فوقانی آسیب برسانند. مورد دیگر ممکن است در تغییرات سیستم ایمنی در طول یک عفونت ویروسی حاد نهفته باشد.»
وی افزود: «هیچ شکی وجود ندارد که افزایش عفونتهای کشنده ویروسی تا حدی با افزایش عفونتهای باکتریایی پیچیده همراه است.»
هنوز واکسن عفونت استرپتوکوکی A تزریق نشده است
مک گیر گفت: «گروه استرپتوکوکی لعنتي، چیزی است که ما باید واكسني برايش داشته باشيم. زیرا در لیست بیماریهای شدیدی قرار دارد. همچنین ميتواند فرد را فوري بيمار كند حتي اگر خيلي سالم باشد.»
محققان در سراسر جهان چندین دهه است که در تلاش برای ساخت واکسن موفق علیه عفونت استرپتوکوکی A هستند، اما چالشهای عمدهای برای عرضهاش به بازار وجود دارد.
مرگ ۴ کودک و بالا رفتن نگرانیهای حاصل از ابتلا به عفونت استرپتوکوکی
- عضویت در کانال تلگرام رسانه هدهد کانادا
- اخبار روز کانادا و اخبار مهاجرت کانادا را در رسانه هدهد دنبال کنید
- هم اکنون شما هم عضو هفته نامه رسانه هدهد کانادا شوید
منبع: سیبیسی